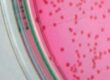

Glucocorticoids are used commonly in many different areas of veterinary medicine. They are necessary drugs in many situations, but should always be used advisedly and with the right dosage. However, you should always be aware of their effects, their side effects to the animal body and their strong influence on laboratory examinations, which we will cover in this edition of the LABOKLIN Aktuell.
In the table 1 are listed different duration times of various Glucocorticoids. Short acting means <12h, intermediate acting means 12-36h and long acting means >36h. The long term effect of cortisone depends on combination of the base and the ester of the steroid, like the long acting glucocorticoids Paramethasone, Betamethasone and Dexamethasone, which duration time lies clearly over 36 hours.
The modality of administering cortisone also has an influence on its efficacy and duration of action. In general there is the possibility to apply Glucocorticoids orally, intramuscularly, subcutaneously, intralesionally (e.g. in oncology), topically or intravenously. (Tab. 2)
The good reasons for using Glucocorticoids (e.g. as anti-inflammatory, anti-pruritic or immuno- suppressive drug) cannot be separated from the many metabolic side effects.
CNS effects:
Euphoria and dysphoria, behaviour and mood modifications, polyphagia and polydipsia and seizure threshold can be lowered.
Gastrointestinal system:
Decreased absorption of calcium and iron salts, increased fat absorption, increased secretion of gastric acid, pepsin and trypsin, vomitus, diarrhoea, gastrointestinal ulcerations and pancreatitis.
Liver:
Increased glycogen deposits within hepatocytes, increased serum levels of liver enzymes like ALT and AST and also g-GT (Gamma Glutamyl Transpeptidase) can be increased. Severe increase of AP (alkaline Phosphatase) is frequently observed: In dogs the thermally stable AP-isoenzyme is induced by endogenous or therapeutically administered Glucocorticoids, but also by many other drugs. The increase can persist up to 2-4 weeks after termination of therapy. For clarification purpose the percentage of thermally stable AP can be determined at your lab. Increased values can be seen in 83-100% of dogs suffering from hyperadrenocorticism.
Musculoskeletal system:
Muscular weakness, atrophy, osteoporosis and weight increase (adrenocortical obesity).
Skin:
Skin atrophy und thinning of dermal tissue, calcinosis cutis, alopecia, formation of comedones, oedema and wound healing disorders
Hematopoietic system:
Involution of lymphatic tissue (species dependent), decreased amounts of lymphocytes (peripheral), monocytes and eosinophils, increased amounts of peripheral neutrophils, erythrocytes and circulating platelets (platelet aggregation is inhibited though), reduced blood coagulation time, inhibited phagocytosis, reduced prostaglandin, bradykinin, histamine and interleukin production.
Cardiovascular system:
Positive inotropic effect, reduced capillary permeability, enhanced vasoconstriction, arterial hypertension (retention of sodium chloride and water) and increased blood pressure (result from vaso-constrictive properties and increased blood volume).
Respiratory system:
Tachypnoe (panting).
- Tab. 1: Table by Donald C.Plumb: Plumb´s Veterinary DrugHandbook, 7th Edition, Wiley-Blackwell, 2011
- Tab. 2: Veterinary indications for glucocorticoid use
- Tab. 3: Monitoring during Glucocorticoid therapy
- Tab. 4: Contraindications
-
Tab. 5: Preperation
*According to publications there is no recommended withdrawal time, however it is stated that there are animals, which could have a decrease in antibody production and due to this false negative test results could occur. Therefore, we recommend maintaining the withdrawal time as for orally applied cortisone.
Renal, fluid and electrolytes:
Increased reabsorption of water, sodium and chloride, increased excretion of potassium and calcium and therefore increased extracellular fluid volume. Also the effect of ADH is inhibited, thus resulting in polyuria.
Bones:
Inhibition of collagen synthesis carried out by fibroblasts, increased resorption of bone, decreased serum calcium level, vitamin D antagonist.
Endocrine system:
Suppression of the hypothalamus-pituitary gland-adrenal cortex axis, secondary hyperadrenocortisismus, secondary induced diabetes mellitus or a significant worsening of an already existing Diabetes mellitus.
Cells:
Stabilization of liposomal and lysosomal membranes, decreased macrophage reaction to migration inhibiting factor response, decreased lymphocyte and cellular response sensitivity to mediators of inflammation and inhibition of fibroblast proliferation.
Reproduction:
Teratogen in early pregnancy and when administered in the latter stages of pregnancy may induce parturition in equine and ruminant animals (less so in dogs and cats).
Ophthalmic system:
Prolonged use can cause increased intraocular pressure and glaucoma, cataracts and exophthalmos.
Adolescence/growth:
Growth inhibitor in young animals (CAVE: use of glucocorticoids in young and growing animals can retard their growth).
Immune system:
Decreased circulating levels of T-lymphocytes, inhibition of lymphokines, inhibition of neutrophils, macrophages and monocytes migration, reduced interferon production and inhibition of phagocytosis and chemotaxis. Glucocorticoids can also antagonize the complement cascade and mask clinical signs of infection with decreased number of mast cells, suppressed histamine synthesis and reduced amount of type 1 allergic effector cells in serum (basophils). Bottom line: immunosuppression and susceptibility to infection (e.g. infections of the urinary tract). (Tab. 3)
Glucocorticoids are pronounced antiinfl drugs, which can cause suppression of symptoms of acute, chronic, immunological or non-immunological infections. Very essential is the membrane stabilizing effect, which is extended to almost all biological membranes. Thereby inhibiting degranulation and releasing of inflamediators, causing a reduction in the capillary permeability and exsudative processes. Another mechanism affects the rapidly occurring inhibition of cyclooxygenase and thereby the synthesis of prostaglandins. Secondary, after a few hours, an additional blockade of the arachidonic acid cascade takes place. This early intervention in the arachidonic acid cascade not only results in the inhibition of the formation of prostaglandins but also of leucotriens. These play an important role in obstructive allergic respiratory diseases because of their vasoconstrictive effect on the bronchia. (Tab. 4)
Glucocorticoids and Allergy Testing
In cats suffering from allergic asthma a two-week withdrawal time from inhaled glucocorticoids is recommended prior to performing an intradermal skin test (IDST) (CHANG et al., 2011).
REEDY (1997) recommends a minimum of 6-8 weeks of withdrawal time after administration of injectable glucocorticoids. CLARKE et al. (2000) also found that dogs treated long term with corticoids and subsequently showed negative results on the ALLERCEPT® Fcε-receptor test, got positive test results after discontinuing of glucocorticoid therapy. Regarding orally given glucocorticoids and their influence on allergy testing KUNKLE (1994) showed that treatment of dogs with prednisone 1 mg/kg SID for 4-6 weeks made a significant reduction of reactions on the intradermal skin test (IDST). Another study showed that prednisolone and also cetirizine significantly influence and lower reactions in the IDST (TEMIZEL, 2011). Oral cortisone also reduces serum IgE levels considerably (SCHIESSL et al., 1998). Withdrawal times are also recommended for topical glucocorticoids and otic solutions containing cortisone. In a study 1% hydrocortisone containing conditioner (ResiCORT® Virbac) was applied once daily for 3 days. After treatment reduced IDST reactions were seen (RIVIERREL, 2000). Another study (BIZIKOVA, 2010) examined the influence of a locally used hydrocortisone aceponate spray (Cortavance® Virbac) on allergy testing. This spray reduced the IDST reactions and caused skin atrophy after long term treatment on all treated areas. Therefore, it is recommended to discontinue the applications for minimum 2 weeks prior to allergy testing.
Treatment with Otomax® (betamethasone containing otic solution) twice daily for 2 weeks reduced IDST reactions significantly in a study with 8 dogs (GINEL, 2007).
Although several withdrawal times regarding glucocorticoids, antihistamines and cyclosporine are discussed in different studies, our LABOKLIN Allergy Team recommends – based on our long clinical and laboratory experience – generally implementing the following withdrawal times prior to allergy testing: (Tab. 5)
Allergy is diagnosed according to clinical signs and accurate medical history, and the causative allergens are determined by allergy testing in order to either avoid them systematically or to perform an allergenspecific immunotherapy (ASIT). Thus, withdrawal times should be maintained to obtain the best possible test results and blood should be collected before any therapy with glucocorticoids is initiated, whenever possible.
Good quality serum can be stored in the refrigerator for a couple of weeks but frozen it can be stored for some months.
An allergy test which is performed during the glucocorticoid withdrawal time can be taken as valid, if it shows positive test results (reaction classes might have to be interpreted higher). In the case of negative test results, it is not possible to judge whether the result is truly negative or false negative because of the influence of glucocorticoids on allergy testing, and re-testing after withdrawal time is recommended.